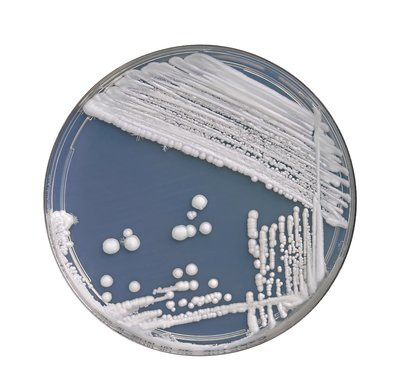
念珠菌中药调理方法,念珠菌用药几天止痒

大约40年前,抗生素成为治病的神奇*弹子**,它们被誉为奇迹药物,就连感冒和青春痘等小病,医生也开抗生素给病患服用,但抗生素不只会杀死致病的细菌,也会杀死益菌,进而干扰体内生态,致使坏菌占据体内。
其中最常见的坏菌是念珠菌,属于酵母型或真菌型(fungus)的病原菌,通常存在于人体内或体表,至于消化道和女性阴道,也会有少量的念珠菌跟好菌共存。
高糖、产酸或缺乏矿物质的饮食,都会助长念珠菌。念珠菌很投机,常会趁虚而入,只要饮食不正确,服用抗生素,或者因服用避孕药而改变体内化学组成,就会成为让念珠菌占上风的温床。
念珠菌最容易侵袭阴道和肠道,而且很快就会蔓延到血液,开始在每个器官建立菌落,引发所谓的全身性感染。高危险人群(念珠菌感染症常见高危险人群包括免疫不全、脏器器官移植及癌症接受化疗后身体虚弱的病人)就算只使用抗生素短短2天,也会加速念珠菌增生。念珠菌菌落增生后,就会产生有毒废物循环全身,毒害并弱化免疫力和内分泌系统。
念珠菌症的症状
念珠菌增生,一般称为念珠菌症或念珠菌感染综合征(CRC,Candida Related Complex),一直跟许多症状有关,包括食物过敏、消化不良、经前综合征、皮肤起疹子、慢性便秘、反复头痛、慢性阴道炎、化学物质和环境过敏性反应、健忘、心智不清(mental fuzziness)、性欲减退等。念珠菌感染综合征会跟其他疾病一起发作,例如慢性疲劳、癌症、艾滋病、EB病毒、支气管炎、肺炎和免疫不全症。

专家估计,每3个美国人就有一个患念珠菌症(妇女约80%都曾患念珠菌症),尤其好发于年轻人群,但大多数人都没想到是念珠菌在作怪。
为了逆转念珠菌增生的情势,必须修复体内环境,以免念珠菌称霸。这有赖两个行动:一是把血液导向碱性且富含矿物质,进而杀光坏菌和投机的寄生生物;二是让好菌收复失土,恢复正常消化。为了重建免疫系统,这两项行动缺一不可,除非改善体内环境,促进好菌生长,否则无助于好菌收复失土。
修复体内生态所面临的阻碍
初次使用抗生素时,几乎可以杀光所有引发感染的菌株,但细菌终究会改变基因组成,开始产生抗药性,一旦随着有抗药性的细菌开枝散叶,势力逐渐壮大,就会有惊人的环境适应力,这时候就很难消灭了。
但其实,只要改变体内环境,这些细菌就无法生存,人体平衡饮食正是会改善体内细菌的栖息地,以免坏菌称霸。
人体滥用抗生素,就如同环境滥用农药,以致害虫对许多农药产生抗药性,农药厂家只好不断调整配方。然而,农药通常也会杀死无害的生物,例如其他昆虫、鸟类和动植物,这就相当于抗生素破坏了体内的好菌一样。
重视益生菌
友善的细菌(又称益生菌),包括乳杆菌(胚芽乳酸杆菌Lactobacillus plantarum和双叉乳酸杆菌Lactobacillus bifidus)以及有益的酵母菌(克菲尔酵母菌Saccharomyces kefir和克菲尔串珠酵母菌Tourla kefir),对许多身体功能来说均不可或缺,可以帮助白细胞对抗疾病,控制肠道里面的腐臭细菌,提供造血所需的重要营养,帮助消化,保护肠黏膜,防止腹泻和便秘,促进排便。益生菌也会制造重要的维生素B,也是维生素B12最主要的来源。

超市、便利店等销售整瓶的益生菌,通常是放在冰箱里保存,以免效果打折。
另外,除非有绝对的必要,否则不要随便服用抗生素。如果你必须服用抗生素,那就要严格照着“人体平衡饮食”去做,等“抗生”素疗法结束后,就必须马上展开“益生”菌疗法。